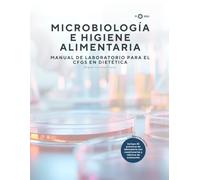
MICROBIOLOGÍA E HIGIENE ALIMENTARIA: MANUAL DE LABORATORIO PARA EL CFGS EN DIETÉTICA

🤖 Chiedi a ChatGPT
Informazioni su "microbiología e higiene"
Dopo la ricerca per il prezzi d'acquisto più economico, 11 offerte sono state trovate.
Sono stati trovati molti offerte in 37 categorie con un fascia di prezzo a partire da 10,40 € a 39,24 €.
I dati relativi "microbiología e higiene"
- I prezzi più bassi trovati in 2 differenti corrieri, incluso amazon-marketplace.it e Amazon.it.
- Nel caso in cui preferissi un articolo da un particolare produttori, puoi trovare 0 corrieri per questo prodotto. Se non hai ancora preso una decisione, puoi anche filtrare i tuoi favoriti produttori e scegliere tra 0 produttori.
- I più offerte (2) sono stati trovati in fascia di prezzo da 10,00 € a 10,99 €.
- Inoltre, altri utenti hanno mostrato interesse verso il seguente prodotto: .
- Personalizza i tuo prodotti scegliendo uno dei 0 ombre.